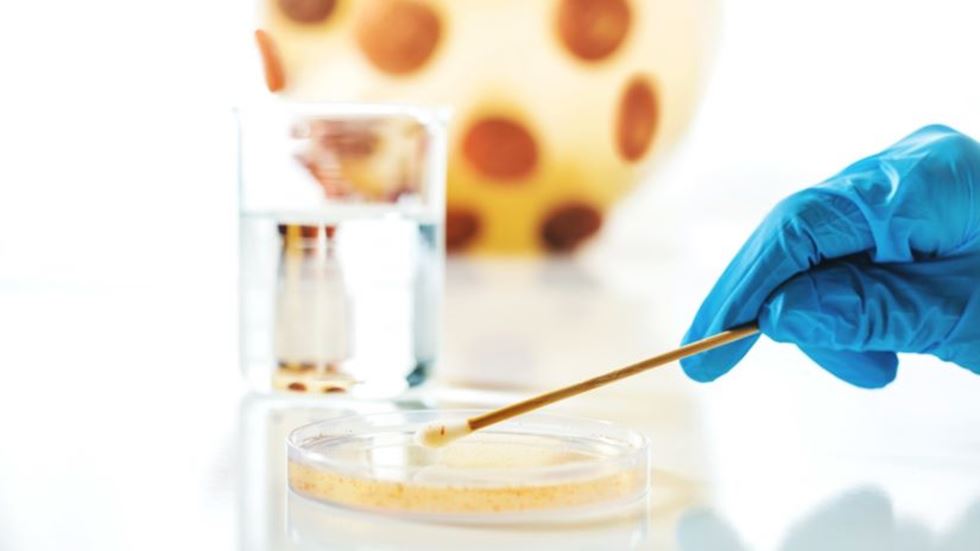

Pågående studier
Kartläggning av studier som sker via ACTION Sweden och studier som stöds av nätverket
RECOVERY – Pneumoni och Influensa
Titel: Randomised Evaluation of COVID-19 Therapy (RECOVERY)
Typ av studie (interventionsstudie/observationsstudie): Interventionsstudie
Studieupplägg: Europeisk multicenterstudie, där patienter som sjukhusvårdas för samhällsförvärvad pneumoni eller influensa randomiseras till att få Dexametason-behandling eller standardbehandling (ej Dexametason). Studien är en plattformsstudie där antal inkluderade patienter inte är fördefinierat och där det också finns möjlighet att randomisera till antiviral behandling vid influensa. Primärt utfallsmått är 28-dagarsmortalitet.
Medverkande centra i Sverige: Stockholm (Karolinska Huddinge, Södersjukhuset, St Göran), Göteborg, Lund, Umeå, Linköping, Örebro och Kalmar.
Medverkande europeiska länder: UK, Sverige, Nederländerna, Frankrike, Belgien, Italien, Spanien, Portugal, Estland, Rumänien.
Hypotes/syfte: Syftet är att studera effekten av Dexametason vid samhällsförvärvad pneumoni och influensa. Vilka patientgrupper har nytta av och vilka patientgrupper kan eventuellt ta skada av att få Dexametason?
Huvudprövare/ansvarig/kontakt: Kristoffer Strålin, kristoffer.stralin@ki.se
ORAL
Titel: ORAL - Partial oral antibiotic treatment for bacterial brain abscess: An open-label randomised non-inferiority trial (ORAL)
Typ av studie (interventionsstudie/observationsstudie): Interventionsstudie
Studieupplägg: 450 patienter totalt varav 70 i Sverige. 2 armar där patienter randomiseras till standardbehandling resp. byte till peroral antibiotika efter 2 veckor.
Medverkande centra: Karolinska, Göteborg, Lund, Uppsala, Linköping, Umeå, Örebro. Utförs i Danmark, Sverige, Nederländerna, Frankrike och Australien.
Hypotes/syfte: Tidig övergång till peroral antibiotikabehandling är lika bra som lång intravenös antibiotikabehandling hos patienter med hjärnabscess.
Huvudprövare/ansvarig/kontakt: PI i Sverige, Pontus Naucler, pontus.naucler@ki.se
Användning av nya antibiotika
Titel: Användning av nya antibiotika vid svenska sjukhus
Typ av studie (interventionsstudie/observationsstudie): Observationsstudie
Studieupplägg: Prospektiv inklusion av patienter som behandlas med ceftazidim-avibaktam, ceftolozan-tazobaktam, meropenem-vaborbaktam, imipenem-relebaktam, cefiderocol eller intravenöst fosfomycin under 12 månader.
Medverkande centra: Göteborg, Linköping, Lund, Solna, Umeå, Uppsala, Örebro.
Hypotes/syfte: Syftet är att kartlägga hur nya antibiotika används på svenska sjukhus. Indikationer för behandling, kliniska samt mikrobiologiska utfall och resistensutveckling kommer att utvärderas.
Huvudprövare/ansvarig/kontakt: Thomas Tängdén och Lisa Faxén, Akademiska sjukhuset. Thomas.Tangden@medsci.uu.se
Farmakokinetik av betalaktamantibiotika
Titel: Farmakokinetik av betalaktamantibiotika hos patienter som behandlas för infektiös endokardit
Typ av studie (interventionsstudie/observationsstudie): Observationsstudie
Studieupplägg: Patienter som behandlas med betalaktamantibiotika för säkerställd eller misstänkt endokardit inkluderas prospektivt. Upprepade provtagningar görs för att kartlägga antibiotikas koncentrationer och farmakokinetik.
Medverkande centra: Göteborg, Lund, Solna, Uppsala.
Hypotes/syfte: Syftet är att med hjälp av matematisk modellering kartlägga hur patientfaktorer påverkar antibiotikas farmakokinetik vilket kan användas för simulering av optimerad och individanpassad dosering till framtida patienter.
Huvudprövare/ansvarig/kontakt: Thomas Tängdén och Lisa Faxén, Akademiska sjukhuset. Thomas.Tangden@medsci.uu.se
COMeBAC – penicillin till pencillinkänsliga S.aureus
Titel: COMeBAC –Randomiserad, kontrollerad klinisk prövning för att jämföra behandling med cloxacillin mot bensylpenicillin vid bakteriemi orsakad av penicillinkänsliga Staphylococcus aureus (PSSA)
Typ av studie (interventionsstudie/observationsstudie): Interventionsstudie.
Studieupplägg: Öppen, randomiserad, kontrollerad studie jämförande behandling med bensylpenicillin och cloxacillin vid PSSA bakteriemi hos vuxna. Dosering och behandlingslängd kommer att följa de riktlinjer som finns i klinisk praxis nationellt idag för respektive infektionsdiagnos. Antal försökspersoner: 420.
Medverkande centra: Lund, Malmö, Kristianstad, Helsingborg, Göteborg, Uppsala, Västerås, Örebro, Karlskrona och Stockholm.
Hypotes/syfte: Syftet är att studera om bensylpenicillin är en bättre behandling vid bakteriemier med penicillinkänsliga S. aureus än kloxacillin.
Huvudprövare/ansvarig/kontakt: Malin Hagstrand Aldman, Infektionskliniken, SUS, Lund, Malin.hagstrand_aldman@med.lu.se
SNAP – världens största kliniska prövning avseende S.aureus bakteremier
Titel: Staphylococcus aureus Nätverk Adaptiv Prövning (SNAP)
Typ av studie (interventionsstudie/observationsstudie): Interventionsstudie.
Studieupplägg: Öppen randomiserad kontrollerad adaptiv plattformsprövning på flera sjukhus i flera länder. Forskningspersoner kan lottas till flera olika interventioner samtidigt. Över tid kan gamla interventioner tas bort och nya interventioner läggas till. Tanken är att denna kliniska prövning skall pågå för evigt eller rekrytera minst 7000 personer globalt.
Medverkande centra: Helsingborg, Malmö, Lund, Karolinska Solna, Östersund, Umeå, Skövde och Västerås.
Hypotes/syfte: Att utvärdera hur en rad olika interventioner påverkar död oavsett orsak inom 90 dagar för personer som drabbats av S. Aureus bakteremi. I nuläget finns följande domäner i Sverige och EU: basantibiotika (PSSA: PcG vs Cloxa, MSSA: Cloxa vs Cefazolin, MRSA: Vanko vs Vanko + Cefazolin), tilläggsantibiotika (5 dagar Klindamycin vs inget tillägg) samt tidig tablettantibiotika (fortsatt intravenös behandling i minst 10 dagar vs byte till tablettbehandling vid dag 7±2 eller 14±2 dagar utifrån infektionsfokus och utläkning).
Huvudprövare/ansvarig/kontakt: Jonas Tverring, Infektionskliniken Helsingborgs lasarett, jonas.tverring@med.lu.se
Hemsida
